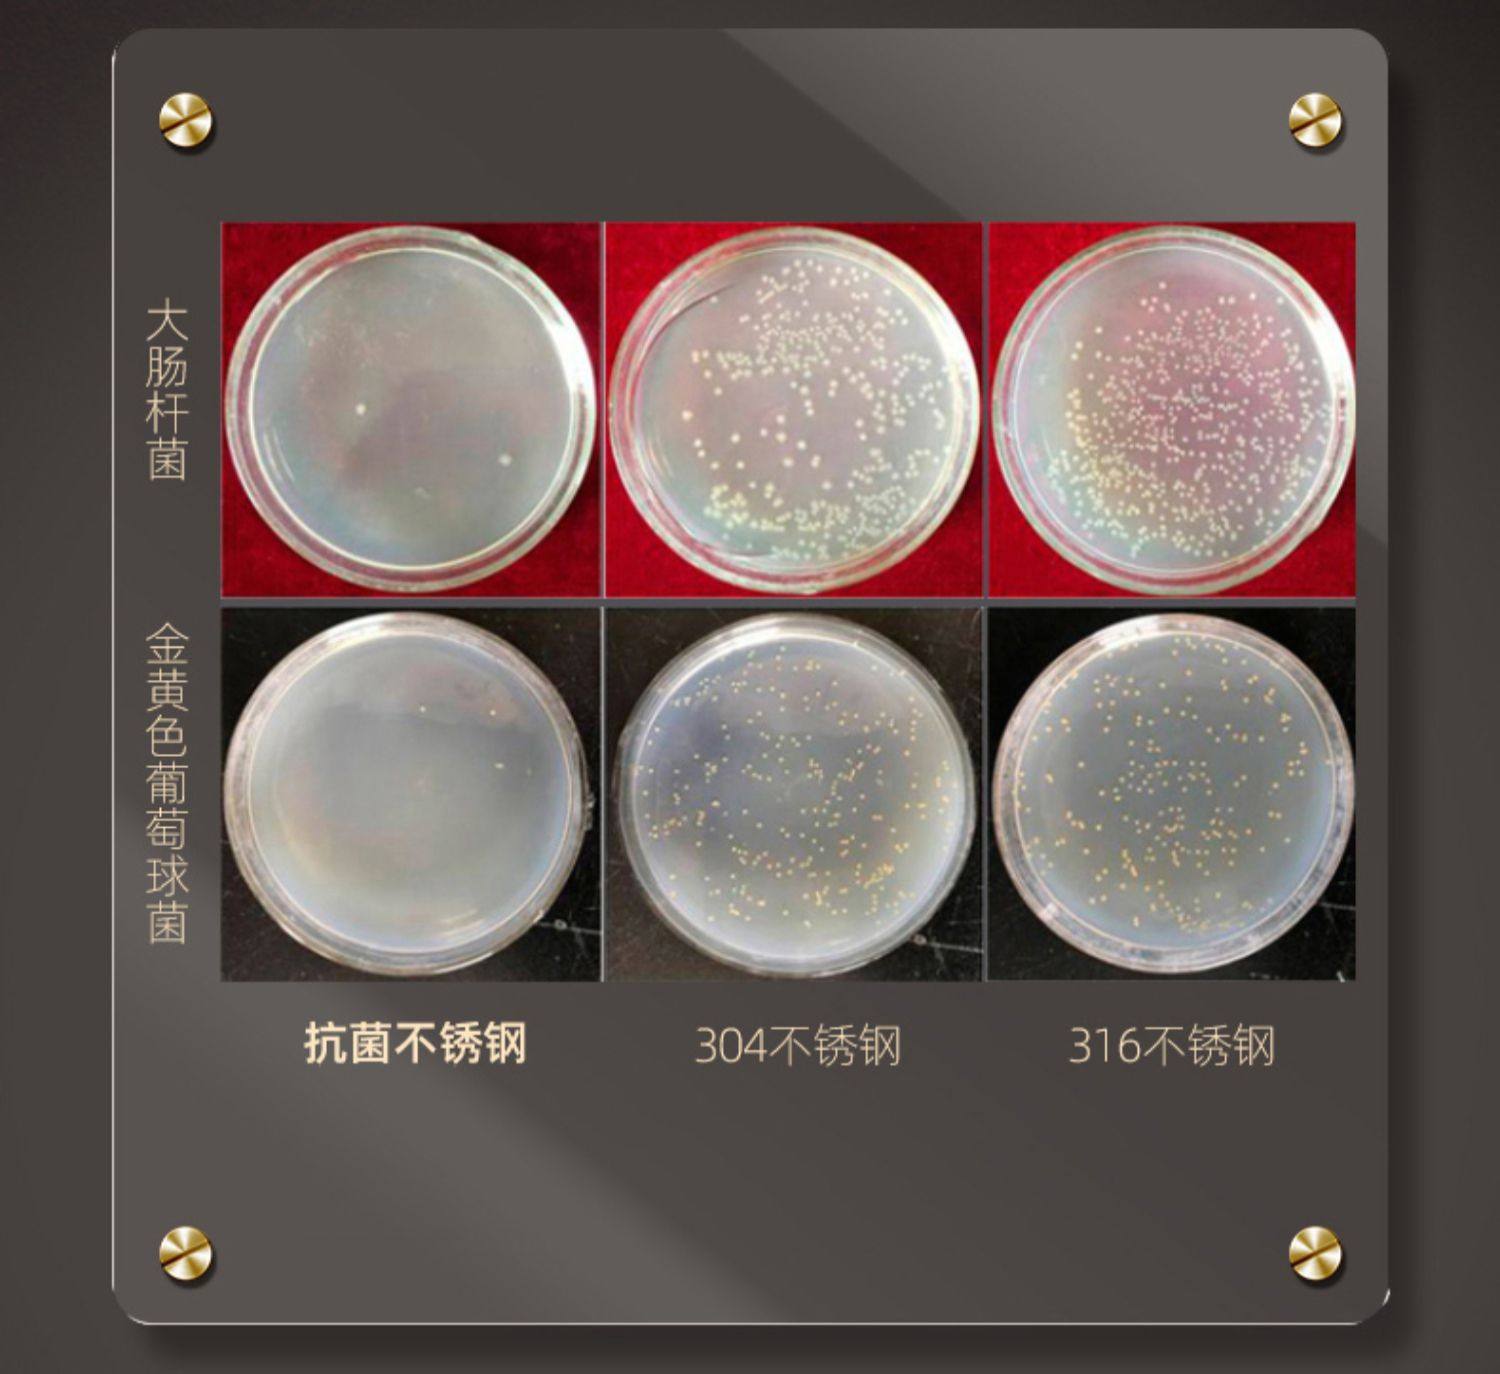

商品詳細介紹

使用方法說明
無
注意事項
「本人已詳細閱讀並完全了解《全球購-海外跨境商品代購規則》的所有條款,並同意遵守以下規範:
歡迎來到全球購!為確保您的權益,請仔細閱讀以下條款與規則。
『購物前須知』
- 本人了解並接受海外代購的特殊性,並確認不會因規則中所列條款(包括但不限於:商品不可取消、折價券使用規則、不可控因素導致訂單取消等)而要求商家賠償或補償。
- 本人勾選並確認後,即視為完全同意規則內容,不得以未閱讀或未理解為由提出爭議或退費要求。
- 本人同意,若商家條款內容未更新,且本次下單條件與上次一致,系統將預設為已勾選確認,但條款內容仍可隨時查看並重新勾選。若條款有更新或與上次下單條件不符,系統將提示本人重新確認並勾選。」
歡迎來到全球購!為確保您的權益,請仔細閱讀以下條款與規則。
『購物前須知』
- 訂單不可取消
一旦訂單狀態顯示「 已出貨」,即表示商品已由國外廠商出貨,無法取消訂單。請謹慎下單。 - 拆封與申訴
請務必全程錄影商品的拆封過程,這將作為您申訴新品瑕疵的重要依據。如無法提供錄影證據,申訴將不予受理。在申訴過程中,請保留商品外箱並妥善保存商品。如商品收回時未能維持原包裝,可能需向您收取10~30%的整新費。 - 送貨範圍與服務
海關物流僅提供至指定地址1樓的配送服務,如要求配送至2樓(含)以上樓層,請提前與客服預約並支付額外費用。 - 家具類商品須知
家具類商品需自行組裝,如需組裝服務,需另行預約並支付額外費用。請確保您有能力或安排合適的人員進行組裝。 - 電器商品電壓規格
帶電類商品通常為220V電壓,若需選購110V電壓商品,請務必事先確認商品標示,恕不受理因選錯規格的退貨申請。 - 運送風險與損傷
海運商品可能因運輸過程出現輕微碰撞痕跡,此類情況不影響使用且不屬於瑕疵範疇,如無法接受,請勿下單。 - 訂單分包與短缺處理
訂單可能分包寄出,抵達時間可能不一致。若發現商品短缺,請立即聯繫客服確認。 - 報關金額與關稅說明
所有訂單均已包含關稅。商品的報關金額可能因品類及報關行的估算而有所不同,這與您的實際購買金額可能存在差異。 - 運費承擔與退費規則
訂單超過5KG以上,將由客服專人聯繫加收運費,運費應由消費者承擔。若發生退貨,已支付的運費將不會退還。 - 廠商客服聯繫時間
廠商客服服務時間為每週一至週五,上午九點至下午六點,並由客服為您轉達問題。您也可以24小時撥打東森免費服務專線:0800-057-999。
- 訂單無法取消及無提供鑑賞期
海外代購是依照消費者要求而提供協助購買商品之服務,係屬於「客製化給付」,依據《通訊交易解除權合理例外情事適用準則》規定不適用《消費者保護法第19條》鑑賞期規定。一旦訂單進入「已出貨」狀態,即無法取消訂單。收到商品後,若與預期不符,亦無法申請退貨或退款。 - 瑕疵商品退換貨規定
若商品存在瑕疵,請於簽收後7日內提出申請,並提供全程拆封錄影作為依據。商品是否為瑕疵將由廠商最終確認。運輸過程中的輕微碰撞痕跡不影響使用,不屬於瑕疵範疇。 - 拒收包裹的後果
因商品為海外寄送,若拒收包裹,包裹將會退回海關並被銷毀,且訂單款項不會退款。請務必在下單前確認收件地址及商品內容無誤。 - 非瑕疵商品退貨手續費
若商品非瑕疵但消費者仍需退貨,一般商品需支付訂單金額的50%作為手續費,且原支付的運費將不予退還。對於家具類商品,需支付訂單金額的60%作為手續費,並支付跨境物流實際運費。請謹慎評估後再下單。(手續費包含:物流費、關稅、金流手續費等)
- 商品規格確認
在結帳前,請再次確認商品的規格型號,或是與客服售前詢問。商品可能有多種規格,且規格不一定皆為主圖商品,請依顯示名稱以及規格圖片所示選購。 - 商品圖片說明
商品詳情頁圖片所示之額外服務(如商品優惠、保固、保修、贈送、安裝、組裝、送上樓等)均由境外廠商提供,全球購僅代為購買,恕不承擔圖片所示服務的責任。全球購為代購平台,無法驗證商品真偽,下單前請先聯繫客服確認,事後反應恕無法受理。 - 通訊類產品
本店代購的3C通訊類商品,包括但不限於(手機、平板電腦、智慧家居裝置(如智慧門鈴、智慧音響)、行車紀錄器、穿戴式裝置(如智慧手環手錶、健康監測設備)、無線網路分享器及物聯網設備),其中部分含中國地區專用APP或功能,以及SIM卡頻段可能與台灣不相容。若不確定是否可使用,請務必於購買前諮詢客服,售後恕不接受因不相容或功能無法使用的退貨申請。 - 保固及維修服務說明
全球購僅作為代購平台,無提供保固及維修服務。如商品需維修,訂購者需將商品寄至國外維修,並承擔跨境運費及維修費用。 - 訂單缺貨、斷貨與取消政策
如因不可抗力因素導致商品缺貨或廠商無法出貨,本店保有取消訂單的權利。若訂單部分商品缺貨,由於代購模式採不同廠商個別出貨,部分缺貨無法取消整筆訂單,敬請見諒,商家將為缺貨部分辦理退款處理。無法受理因缺貨要求取消整筆訂單。 - 配送時間與緊急需求
訂單付款完成後,商品將於完成付款後翌日起算10至25個工作天內送達台灣本島,不包含海關查驗或其他不可抗力因素影響的延誤。本店不提供急件配送服務,無法因此要求取消訂單。 - 運費政策與額外收費
訂單達到免運條件後,運費將涵蓋關稅及5公斤以內包裹的基本運費。若包裹最終稱重超過5公斤,超重部分將依據集運倉運費計算公告(https://m.bcatlogistics.com/single?id=115)依照材積重量加收運費。客服人員將在收到加收運費通知後與您聯繫。若於收到收費通知D+5日內無法聯繫上您或未得到回覆,訂單將直接取消,包裹將進行逆物流退回廠商。此外,消費者需承擔大陸端的往返運費(約新台幣200至2000元不等)。若未支付逆物流費用,將無法進行退款作業。建議您在下單前先與商家客服確認運費預估金額。 - 「全球購折價券及運費折抵券,為消費者免費領取,視為附條件使用的優惠券,僅限訂單成功完成後生效。若因斷貨、缺貨等不可控因素導致訂單取消,折價券/運費折抵券因交易未成立而失效,恕不返還。消費者領取及使用本折價券,即視為同意相關活動規則及限制。」
- 運費折抵券僅能將運費折抵至 0 元,無論領取面額大小,且每張折抵券僅限單次使用。
- 服務與責任範圍聲明:
本平台提供的服務以網站公佈的規則與條款為準,未明確列出的服務項目即視為不提供。客戶下單即表示已了解並接受此規則,任何超出範圍的要求恕無法受理。 - EZWAY實名認證
訂單付款後,請於7日內依照政府規定完成EZWAY實名認證。未完成認證可能導致海關銷毀商品且不退還貨款。
- 個人資料保護政策
您的個人資料將用於進口報關及配送,並依《個人資料保護法》嚴格管理。 - EZWAY實名認證流程
依台灣海關規定,購買海外代購商品需下載並通過EZWAY APP完成實名認證。收到EZWAY報關通知後,請確認APP中的姓名、電話及身份證字號與註冊資料一致。舊用戶需補登健保卡號及出生年月。 - 未完成認證的後果
7天內未完成認證,可能導致海關銷毀商品且不退還貨款,並可能處以罰鍰。相關損害將由消費者自行承擔。 - 認證協助與支持
更多EZWAY實名認證說明可參考東森購物說明頁:etu.tw/VSMzug。如需協助,可加入跨境物流客服諮詢Line@bbcat。 - 清關延誤風險提示
清關時間不穩定,可能因各種因素延誤,敬請事先評估並諒解。 - 申報不符的法律風險
為避免法律糾紛及罰款,請勿隨意或為了拒收而點選“申報不符”。報關行是依據您的訂單進行申報,若消費者故意點選申報不符,將由消費者自行負擔法律責任。